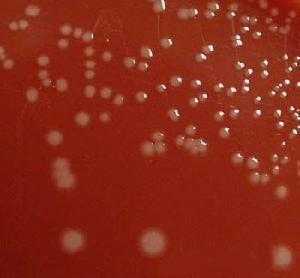
氟氧頭孢鈉

適應症
 扁桃體發炎
扁桃體發炎功用作用
 注射用氟氧頭孢鈉
注射用氟氧頭孢鈉抗菌譜主要包括葡萄球菌、鏈球菌(腸球菌除外)、肺炎鏈球菌、消化鏈球菌、卡他球菌、淋球菌、大腸桿菌、克雷白桿菌、變形桿菌、流感嗜血桿菌以及擬桿菌等。
本品靜滴0.5g、1g或2g,歷時1小時,最高血藥濃度分別為20μg/ml、45μg/ml和90μg/ml,t1/2(β)分別為73.4、49.2和40分鐘。如以上量點滴2小時,則最高血藥濃度分別為10μg/ml、24μg/ml和48μg/ml,t1/2(β)分別為46.2分鐘、57分鐘和69分鐘。體內分布較廣泛,可進入膽汁、痰液、腹水、骨盆死腔滲出液以及子宮及附屬器官、中耳黏膜和肺組織中。體內少部分代謝,大部分(85%)以原形經腎排泄。腎功能減退者排出減少。套用於上述敏感菌所致的咽炎、扁桃體炎、支氣管炎、肺炎、腎盂腎炎、膀胱炎、前列腺炎、膽道感染、腹膜炎、盆腔炎、子宮及附屬組織炎症、中耳炎、創口感染、心內膜炎及敗血症等。
用法用量
輕症成人1日量1~2g,分成2次靜注;兒童1日60~80mg/kg,分2次靜注或靜滴。
重症成人1日4g,分2~4次用;兒童1日150mg/kg,分3~4次用。
注意事項
 氟氧頭孢鈉過敏
氟氧頭孢鈉過敏2、不良反應有腎功能減退(BUN上升),造血系統變化(紅細胞減少、粒細胞減少、血紅蛋白降低、嗜酸細胞增多、血細胞比容下降、血小板減少或增多,並罕見溶血性貧血),肝酶單項或多項上升,噁心、嘔吐、腹瀉、軟便、偽膜性腸炎(罕見),皮疹及瘙癢,過敏性休克,藥物熱,咳嗽、呼吸困難及肺X光影象改變症狀,口腔炎,頭暈、倦怠、血或尿澱粉酶升高以及注射局部靜脈炎等。
3、對孕婦及新生兒的用藥安全性尚未確定,一般不宜套用。
藥理作用
淋球菌圖譜
淋球菌圖譜藥物相互作用
本品與氨基糖苷類抗生素或呋塞米等強利尿劑同用時,可出現腎功能異常或增加腎毒性。規格
注射劑:每瓶0.5g, 1.0g.
治療案例-肺炎-抗生素套用
小兒支原體肺炎的治療與一般肺炎的治療原則基本相同,採取綜合治療措施。包括一般治療、對症治療、抗生素的套用、腎上腺皮質激素,以及肺外併發症的治療等5個方面。
一般治療
 肺炎細菌
肺炎細菌護理保持室內空氣新鮮,供給易消化、營養豐富的食物及足夠的液體。保持口腔衛生及呼吸道通暢,經常給患兒翻身、拍背、變換體位,促進分泌物排出、必要時可適當吸痰,清除粘稠分泌物。
氧療對病情嚴重有缺氧表現者,或氣道梗阻現象嚴重者,應及時給氧。其目的在於提高動脈血氧分壓,改善因低氧血症造成的組織缺氧。給氧方法與一般肺炎相同。
對症處理
 肺炎胸片
肺炎胸片平喘對喘憋嚴重者,可選用支氣管擴張劑,如氨茶鹼口服,4~6mg/(kg﹒次),每6h1次﹔亦可用舒喘靈吸入等。
抗生素的套用
根據支原體微生物學特徵,凡能阻礙微生物細胞壁合成的抗生素如青黴素等,對支原體無效。因此,治療支原體感染,應選用能抑制蛋白質合成的抗生素,包括大環內脂尖、四環素類、氯黴素類等。此外,尚有林可黴素、氯林可黴素、萬古黴素、氟氧頭孢鈉及磺胺類如SMZxo等可供選用。
 卡氏肺孢子蟲肺炎
卡氏肺孢子蟲肺炎靜脈注射紅黴素乳糖酸鹽300mg,4min的血濃度平均為40.9μg/ml,2h後為2.6μg/ml,6h後為0.32μg/ml。如每12h連續靜脈滴注紅黴素乳糖酸鹽1g,則8h後的血藥濃度可維持4~6μg/ml。而痰中平均嘗試為2.6(0.9~8.4)μg/ml。紅黴素主要經膽汁排泄,部分可從腸道內重新吸收。相當量的紅黴素在肝內代謝滅活。口服給藥量的2.5%和注射給藥的15%以活性物質自尿中排出。血液透析和腹膜透析皆不能將紅黴素自體內清除。在使用紅黴素製劑時應注意其毒副作用。各種口服製劑皆可引起噁心、嘔吐、腹痛、腹瀉等胃腸道症狀﹔靜脈滴注時可發生血栓性靜脈炎﹔偶有過敏反應發生,表現為藥物熱、麻疹等。值得注意的是紅性黃疸,往往在給藥14~21d產生上腹疼痛、噁心嘔吐,相繼出現發熱、黃疸、白細胞及嗜酸性粒細胞增多,血清膽紅質和轉氨增高,停藥後2~3d可恢復正常,但再給藥又可重新出現上述症狀。另外,大劑量紅黴素的套用偶可引起耳鳴和暫時性聽覺障礙,一般發生於靜脈給藥或有腎功能減退和(或)肝臟損害者。嬰幼兒口服無味黴素後可出現增生性幽門狹窄,口服紅黴素後也有出現假膜性腸炎者。套用紅黴素期間尿中兒茶酚胺、17-羥類固醇和血清轉氨有增高現象,血清葉酸和尿雌二醇有降低情況。若與茶鹼類藥物同用時,有增加茶鹼和血液中濃度的作用。所以,在合用茶鹼類藥物時,應減量使用或避免合用。
 肺炎患者胸片
肺炎患者胸片四環素類抗生素支原體感染雖有肯定療效,但其毒副作用較多,尤其是四環素對骨骼和牙生長的影響,即使是短期用藥,四環素的色素也能與新形成的骨和牙中的鈣相結合,使乳牙黃染。故不宜在7歲以前兒童時期套用。
氯黴素和碘胺類因為治療支原體感染的療程較長,而氯黴素類、磺胺類抗菌藥物毒副作用較多,不宜長時間用藥,故臨床上較少用於治療支原體感染。
氟酮類近年來有用氟酮類(fluroqumolone)藥物治療支原體感染的報導。氟酮類屬於合成抗菌藥,通過抑制DNA鏇轉,阻斷DNA複製發揮抗菌作用。環丙氟酸(ciproflaxacin)、氧氟沙星(ofloxacin)等藥物在肺及支氣管分泌物中濃度高,能穿透細胞壁,半衰期長達6.7~7.4h。抗菌譜廣,對支原體有很好的治療作用。前者10~15mg/(kg﹒d),分2~3次口服,也可分次靜滴﹔後者10~15mg/(kg﹒d),分2~3次口服,療程2~3周
參考文獻
1、中國醫學藥典 第二部。
2、氟氧頭孢鈉的合成--《河北化工》2006年05期。
3、浙江臨床醫學2003年2月第5卷第2期。
